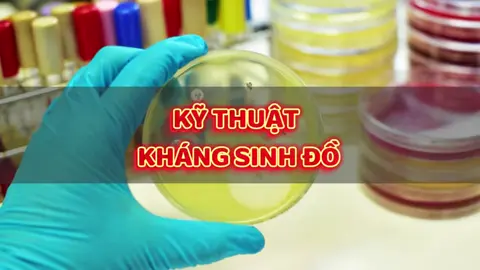
Kỹ thuật kháng sinh đồ đĩa giấy #khangsinh #khangthuoc #khangsinhdo #visinh #visinhlamsang

blueworld_store
Region: FR
Tuesday 18 November 2025 07:25:19 GMT
2340
129
1
5
Music
Download
Comments
blueworld_store :
Maillot disponible en bio🔥
2025-11-18 07:26:29
0
To see more videos from user @blueworld_store, please go to the Tikwm
homepage.